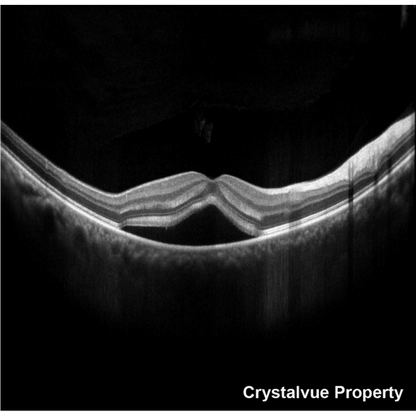
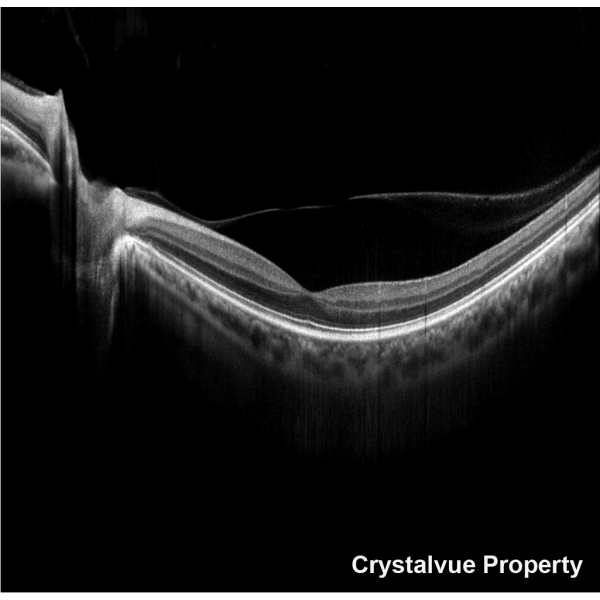

1
/
of
8
VISION 700 Automatic Optical Coherence Tomography - Crystalvue
VISION 700 Automatic Optical Coherence Tomography - Crystalvue
OCT and Fundus Camera Integrated
Crystalvue Vision 700 is a fully-automated, non-contact, high resolution tomographic and biomicroscopic imaging device. It also incorporates a non-mydriatic digital fundus camera and a built-in Windows 10 OS computer.
Fully Automatic Image Capture
Simply tap the pupil on the screen, Vision 700 will start tracking. With a single tap, Vision 700 can automatically align, focus, track, capture images and provide measurement results for Macula OCT and Disc OCT.
High Quality Images with 80k Hz A-Scan
Vision 700 captures and generates high-resolution OCT image and 12 MP high quality true color retinal photos.
En Face Viewer
Vision 700 OCT/Fundus overlay feature can be applied to any designated area rather than merely the fovea.
3D Viewer
Vision 700 is capable of reconstructing the retinal tissue in 3D space for inspection from a user-defined perspective and scale.
10 Scan Modes
Vision 700 provides measurement of posterior ocular structures, including retina, retinal nerve ber layer, macula and optic disc as well as imaging of anterior ocular structures. Users can select up to 10 Scan Modes.
Various Comprehensive Analysis Reports
Vision 700 offers comprehensive analysis reports for each scan mode, including TSNIT, AVERAGE and ONH in 3D Optic Disc mode; THICKNESS, ETDRS and GCC in 3D Macula mode.
Vision 700 offers comprehensive analysis reports for each scan mode, including TSNIT, AVERAGE and ONH in 3D Optic Disc mode; THICKNESS, ETDRS and GCC in 3D Macula mode.
3D Wide Report
The wide scan range of 12x9 mm is supported.
The wide scan range of 12x9 mm is supported.
AI-Based Trend Analysis
Vision 700 provides AI-based trend analysis with up to four measures of both eyes in 3D Macula or 3D Optic Disc mode, giving clinicians more diagnostic options.
Pachymetry and Angle Mode
Vision 700 performs auto measurement for Pachymetry OCT and anterior ocular when the CAM (optional accessory) is attached.
Pachymetry and Angle Mode
Vision 700 performs auto measurement for Pachymetry OCT and anterior ocular when the CAM (optional accessory) is attached.
Manual Mode
Besides Auto mode, Vision 700 also supports Manual mode for OCT measurements.
Built-in Photo Edit Functions
Users are able to edit disc, cup border, and layers to reanalyze the result. There are also multiple filters including RGB, negative film, and red-free for users to apply.
Share